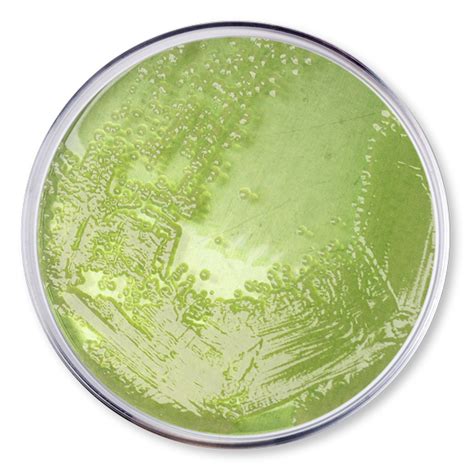

Pseudomonas Spp.: Full Form And Meaning
Pseudomonas spp.: Full Form and Meaning
Hey everyone! Ever stumbled upon “Pseudomonas spp.” and wondered what on earth that means? You’re not alone, guys. It’s a term you’ll often see in microbiology, especially when talking about bacteria. So, what is the full form of Pseudomonas spp. , and why should you care? Let’s dive in!
Table of Contents
Unpacking “Pseudomonas spp.”
Alright, let’s break down this scientific jargon. “ Pseudomonas ” is the genus name for a group of bacteria. Think of it like a last name for a whole family of microbes. These bacteria are pretty common and can be found just about everywhere – in soil, water, and even on plants and animals. Some are harmless, but others can cause infections, especially in people with weakened immune systems. Now, what about the “ spp. ”? This little abbreviation is super important. It stands for species pluralis , which is Latin for “plural species.” So, when you see “Pseudomonas spp. ”, it basically means “one or more species within the Pseudomonas genus.” It’s a way for scientists to refer to the genus as a whole without having to list every single species, which, trust me, is a lot !
Why is Knowing the Full Form Important?
So, why does this matter? Understanding that “ Pseudomonas spp. ” refers to multiple species within the Pseudomonas genus is crucial for a few reasons. Firstly, it highlights the diversity within this bacterial group. Not all Pseudomonas are created equal. Some are beneficial, aiding in bioremediation (cleaning up pollution), while others, like Pseudomonas aeruginosa , are notorious pathogens. Knowing it’s “spp.” reminds us that we’re dealing with a broad category, and further identification is often needed to understand the specific risks or benefits. It’s like saying “dog breeds” – you know it’s a dog, but you need to specify if it’s a Golden Retriever or a Chihuahua to understand its characteristics. The same goes for bacteria. This level of detail is vital in fields like medicine, environmental science, and agriculture. For instance, in a hospital setting, identifying the specific species of Pseudomonas causing an infection is key to choosing the right antibiotic. A broad “Pseudomonas spp.” might indicate a potential problem, but it’s the specific species that dictates the treatment plan. Similarly, in environmental studies, knowing if a particular Pseudomonas species is degrading a pollutant or contributing to its spread makes a huge difference.
The Fascinating World of Pseudomonas Bacteria
The Pseudomonas genus is incredibly diverse and fascinating. These bacteria are typically rod-shaped and Gram-negative, meaning they have a specific cell wall structure that stains pinkish-red with the Gram stain technique. What’s really cool is their metabolic versatility. They can survive and thrive in a wide range of environments, including those that are harsh or contain toxic substances. Many Pseudomonas species are aerobic, meaning they need oxygen to live, but some can switch to anaerobic respiration when oxygen is scarce. This adaptability is a major reason for their widespread distribution.
Common Pseudomonas Species and Their Roles
When we talk about “ Pseudomonas spp. ”, we’re encompassing a vast array of species. Some are quite famous (or infamous!), while others are less well-known but play important ecological roles. Let’s look at a few:
- Pseudomonas aeruginosa : This is probably the most well-known species, and unfortunately, for the wrong reasons. P. aeruginosa is an opportunistic pathogen, meaning it typically infects individuals with compromised immune systems, such as those with cystic fibrosis, cancer patients undergoing chemotherapy, or burn victims. It’s a common cause of hospital-acquired infections, affecting the lungs, urinary tract, and wounds. Its resistance to antibiotics is a major concern in healthcare.
- Pseudomonas putida : Unlike its notorious cousin, P. putida is often considered a beneficial bacterium. It’s known for its remarkable ability to degrade a wide variety of organic compounds, including pollutants like toluene and camphor. This makes it a valuable tool in bioremediation , where scientists use microorganisms to clean up contaminated sites. It’s also used in industrial processes for producing chemicals.
- Pseudomonas fluorescens : This species is frequently found in soil and water. It can promote plant growth by producing compounds that suppress fungal diseases and solubilize phosphate, making it more available for plant uptake. P. fluorescens is also used as a probiotic in agriculture.
- Pseudomonas syringae : This group of bacteria is primarily known for causing diseases in plants. Different strains can infect a wide range of crops, leading to leaf spots, blights, and wilts. Interestingly, some strains of P. syringae have ice-nucleating proteins that can facilitate ice formation at temperatures above freezing, contributing to frost damage in plants.
As you can see, the term “ Pseudomonas spp. ” is a catch-all that covers bacteria with vastly different impacts, from life-threatening infections to crucial environmental and agricultural roles. That’s why, in many contexts, scientists will go the extra mile to identify the specific species involved.
The Science Behind the “spp.”
Let’s get a bit more technical for a moment, guys. The binomial nomenclature system, established by Carl Linnaeus, is how we name organisms. It uses a two-part name: the genus (like Pseudomonas ) and the species (like aeruginosa ). So, Pseudomonas aeruginosa is the full scientific name for one specific type of Pseudomonas . But what happens when you want to refer to all the species within a genus without listing them? That’s where “spp.” comes in.
When and Why Use “spp.”?
Scientists use “spp.” when:
- Referring to the Genus Generally : If a study or discussion is about the Pseudomonas genus as a whole, its general characteristics, or its prevalence across various environments, using “spp.” is efficient and accurate. For example, “ Pseudomonas spp. are commonly found in aquatic environments.”
- Unidentified or Multiple Species Involved : If researchers have isolated bacteria belonging to the Pseudomonas genus but haven’t identified the exact species, or if multiple species are present and their individual roles aren’t distinct for the purpose of the study, “spp.” is used. For example, “Water samples were screened for the presence of Pseudomonas spp.”
- General Ecological or Clinical Significance : When discussing the overall ecological impact or general clinical significance of the genus, “spp.” is appropriate. For instance, “The presence of Pseudomonas spp. in drinking water can indicate potential contamination.”
It’s important to remember that “spp.” is always used in the plural, referring to multiple species. If you were referring to just one species, you would use its full scientific name (e.g., Pseudomonas putida ). And if you wanted to refer to just one specific, but unnamed, species, you might see “sp.” (singularis), though this is less common than “spp.”
Beyond the Full Form: Clinical and Environmental Significance
Understanding the full form of Pseudomonas spp. is just the first step. The real meat is in understanding their implications. In clinical settings, the emergence of multidrug-resistant (MDR) Pseudomonas strains, particularly P. aeruginosa , is a major global health challenge. These bacteria can develop resistance to nearly all available antibiotics, making infections extremely difficult, and sometimes impossible, to treat. This drives research into new antimicrobial strategies and emphasizes the importance of infection control in hospitals.
On the environmental front, Pseudomonas species play critical roles in nutrient cycling and decomposition. Their ability to break down complex organic molecules makes them invaluable for natural cleanup processes. Researchers are actively exploring how to harness the metabolic capabilities of specific Pseudomonas species for biotechnological applications, such as producing biofuels, enzymes, and biodegradable plastics. The challenge lies in controlling these versatile microbes and ensuring that beneficial strains are promoted while pathogenic ones are managed.
Conclusion: Why “Pseudomonas spp.” Matters
So, there you have it, guys! The full form of Pseudomonas spp. isn’t just a random string of letters; it’s a scientific shorthand that tells us we’re talking about one or more species within the Pseudomonas bacterial genus. This understanding is fundamental for anyone delving into microbiology, medicine, or environmental science. It reminds us of the incredible diversity within bacterial genera and the critical need for specific identification when dealing with health or environmental concerns. From causing serious infections to cleaning up our planet, Pseudomonas species are a powerful reminder of the complex and vital microbial world that surrounds us. Keep exploring, keep learning, and don’t be afraid of a little scientific jargon – it’s often the key to unlocking some seriously cool knowledge!